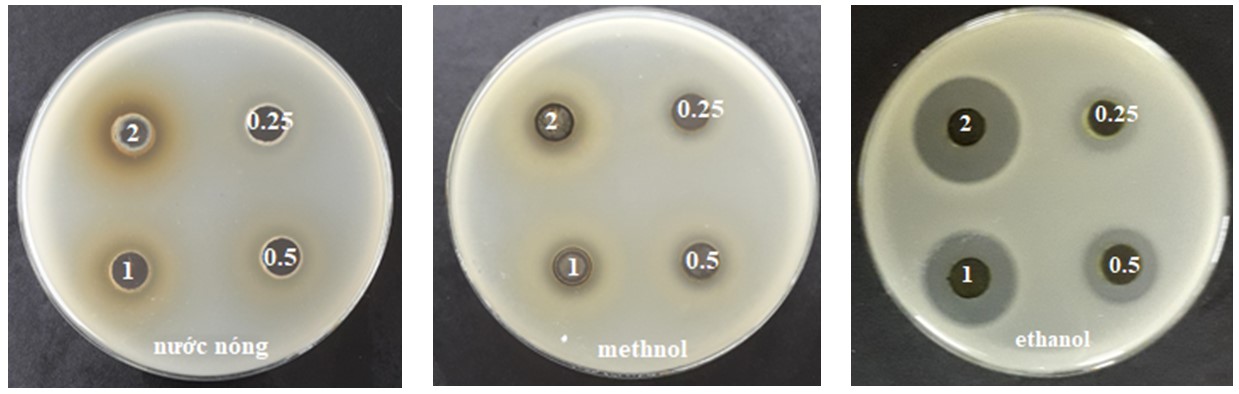

Trần Thị Hồng1, Phạm Thị Huế2, Nguyễn Thị Thanh Hà3, Nguyễn Thanh Hải2*
1Viện kiểm định Quốc gia Vắc xin và Sinh phẩm y tế
2Khoa Công nghệ sinh học, Học viện Nông nghiệp Việt Nam
3Khoa Thú y, Học viện Nông nghiệp Việt Nam
*Tác giả liên hệ: Nguyễn Thanh Hải
– Số ĐT: 0914598399
– Email: nthaicnsh@vnua.edu.vn
TÓM TẮT
Xuyên tâm liên (Andrographis paniculata) là dược liệu có được ứng dụng nhiều trong các bài thuốc điều trị nhiễm khuẩn và nâng cao sức khỏe. Trong nghiên cứu này, chúng tôi tiến hành khảo sát hoạt tính kháng khuẩn, cũng như đánh giá hàm lượng polyphenol và hoạt tính chống oxi hóa của cây thuốc này nhằm bước đầu làm rõ các tiềm năng ứng dụng của chúng. Bột xuyên tâm liên được chiết xuất với 6 dung môi gồm nước nóng, ethanol, methanol, ethyl acetate, acetone và hexane. Hoạt tính kháng khuẩn được khảo sát bằng phương pháp đục giếng khuếch tán trên thạch, thử nghiệm với các vi khuẩn Bacillus subtilis ATCC 6633; Geobacillus stearothermophilus ATCC 7953; Pseudomonas aeruginosa ATCC 9027; Staphylococcus aureus ATCC 25023; Staphylococcus aureus ATCC 25923; Escherichia coli ATCC 85922; Escherichia coli ATCC 35218; Escherichia coli ATCC 25922 và Salmonella ATCC 13311. Hàm lượng polyphenolvà hoạt tính chống oxi hóa được quy đổi về số mg acid chlorogenic tương đương và số mg VTME tương đương có trong 100 mg bột dược liệu, sử dụng các thuốc thử lần lượt là Folin Ciocalteu và 1,1-diphenyl-2-picrylhydrazyl (DPPH). Kết quả cho thấy các dịch chiết từ dược liệu xuyên tâm liên có hoạt tính kháng khuẩn, trong đó, dịch chiết với ethanol cho tác dụng ức chế vi khuẩn tốt nhất (có vòng vô khuẩn với mọi vi khuẩn thử nghiệm, đạt cao nhất là 18.81±2.22 mm, với vi khuẩn Escherichia coli 25922). Các dịch chiết cho hàm lượng polyphenol và hoạt tính chống oxi hóa cao gồm methanol, nước nóng và ethanol, trong đó hàm lượng polyphenol cao nhất là của dịch chiết với methanol (đạt 0.270±0.019 mg acid chlorogenic tương đương / 100 mg bột dược liệu), và hoạt tính chống oxi hóa mạnh nhất là của dịch chiết với nước nóng, đạt 0.691±0.115 mg VTME tương đương/ / 100 mg bột dược liệu).
Từ khóa: xuyên tâm liên, kháng khuẩn, polyphenol, hoạt tính chống oxi hóa, chiết xuất.
A study to investigate the antibacterial effects, polyphenol contents and antioxidant activities of extracts from Andrographis paniculata medicinal plants
ABSTRACT
Andrographis paniculata is a traditional medicine plant which has been known for various beneficial properties, such as the inhibition on bacterial growth and the health enhancement properties. This study was carried out to evaluate the antibacterial effects, polyphenol contents and antioxidant activities of extracts from Andrographis paniculata plant materials, so as to partly explain its traditional application. Plant materials were extracted with 6 solvents: hot water, ethanol, methanol, ethyl acetate, acetone and hexane. We applied the agar-well-diffusion method to evaluate the inhibitory effects of extracts on several bacteria, including: Bacillus subtilis ATCC 6633; Geobacillus stearothermophilus ATCC 7953; Pseudomonas aeruginosa ATCC 9027; Staphylococcus aureus ATCC 25023; Staphylococcus aureus ATCC 25923; Escherichia coli ATCC 85922; Escherichia coli ATCC 35218; Escherichia coli ATCC 25922 and Salmonella ATCC 13311. Reagents, such as Folin Ciocalteu and 1,1-diphenyl-2-picrylhydrazyl (DPPH), were used to measure the polyphenol contents and antioxidant activities of the extracts, which were then respectedly converted to mg acid chlorogenic equivelent and mg VTME equivelent per 100 mg plant powder. The results showed that extracts from Andrographis paniculata showed antibacterial effects, in which the ethanol extract showed the highest antibacterial effects on bacteria, as it induced inhibitory zones on all testes bacteria, with the largest one was on Escherichia coli ATCC 25922 (18.81±2.22 mm). Extracts with high polyphenol contents and antioxidant activities were methanol, hot water and ethanol, in which the highest polyphenol content belonged to methanol extract (with the value reached to 0.270±0.019 mg acid chlorogenic equivelent per 100 mg plant powder), and the strongest antioxidant activity belong to hot water extract (with the value reached to 0.691±0.115 mg VTME equivelent per 100 mg plant powder).
Key words: Andrographis paniculata, antibacterial effects, polyphenol, antioxidant activity, extract.
- ĐẶT VẤN ĐỀ
Theo quan niệm truyền thống kháng sinh được định nghĩa là những chất do các vi sinh vật (vi khuẩn, nấm, xạ khuẩn…) tạo ra có khả năng ức chế sự phát triển hoặc tiêu diệt vi khuẩn. Hiện nay, khoa học kĩ thuật ngày càng phát triển kháng sinh không chỉ được tạo ra bởi các vi sinh vật mà còn được tạo ra bằng quá trình bán tổng hợp hoặc tổng hợp hóa học. Nguồn kháng sinh này được sử dụng không hợp lý, có phần lạm dụng kháng sinh gây hiện tượng kháng sinh, tồn chất kháng sinh trong thực phẩm, chăn nuôi. Ngày nay có càng nhiều mối quan tâm đối với việc tìm kiếm các chất kháng khuẩn có nguồn gốc tự nhiên. Đặc biệt các cây dược liệu, chúng cho ít tác dụng phụ, khả năng kháng chậm hơn, an toàn khi sử dụng.
Xuyên tâm liên có tên khoa học là Andrographis paniculata (Burm.f.) Wall. ex Nees (đồng nghĩa Justicia paniculata (Burm.f.) Nees ), có tên gọi khác là công cộng, lam khái liên, cây lá đắng, khổ đàm thảo, nhất kiến kỷ,… thuộc họ Ô rô (Acanthaceae). Xuyên tâm liên là cây thuốc quan trọng và được sử dụng rộng rãi trên khắp thế giới.
Xuyên tâm liên được biết đến là dược liệu có hoạt tính kháng sinh với nhiều loại vi khuẩn, làm tăng lượng bạch cầu, có tác dụng giảm đau tương tự như aspirin. Thường dùng trị cảm sốt, cúm,… Cũng được dùng để chữa bệnh cho gia súc gia cầm. Xuyên tâm liên là vị thuộc được thế giới đưa vào nghiên cứu bệnh AIDS. Xuyên tâm liên có tác dụng chống COVID- 19,tại Thái Lan cuộc thử nghiệm lâm sàng đầu tiên đã được Viện Nghiên cứu y học cổ truyền Thái Lan tiến hành trên những bệnh nhân đã biểu hiện triệu chứng nhiễm COVID-19 nhẹ như đau họng, nhức đầu, ho hay sổ mũi. Người bệnh được cho uống 180mg Xuyên tâm liên/ngày, chia đều làm 3 lần vào lúc 6 giờ sáng, 2 giờ chiều và 10 giờ tối, uống liên tục trong 5 ngày. Cuộc thử nghiệm cho kết quả khả quan, trong vòng 3 ngày kể từ khi sử dụng Xuyên tâm liên tình trạng sức khỏe của các tình nguyện viên mắc COVID-19 đều được cải thiện.
Bên cạnh tác dụng kháng khuẩn, các nhà nghiên cứu cũng còn quan tâm đến hàm lượng polyphenol và hoạt tính chống oxy hoá khi khảo sát dược liệu. Quá trình sản xuất và tích lũy quá mức các gốc tự do trong cơ thể là nguyên nhân chính dẫn đến lão hóa và các bệnh thoái hóa như bệnh đái tháo đường, ung thư, xơ vữa động mạch, bệnh tim mạch…[1]. Các chất chống oxy hóa tổng hợp (như butylated hydroxyanisol và butylated hydroxytoluene) sử dụng trong công nghiệp thực phẩm lại tạo ra nhiều tác hại trên sức khỏe do độc tính tiềm tàng [2]. Trong khi đó, các hợp chất polyphenol và các thành phần có khả năng chống oxi hóa của thực vật thường được cho là an toàn và tạo ra nhiều các khía cạnh tích cực cho sức khỏe [3]. Vì thế trong nghiên cứu này, bên cạnh khả năng ức chế vi khuẩn, chúng tôi cũng đồng thời khảo sát hàm lượng polyphenol và hoạt tính chống oxy hoá của dược liệu xuyên tâm liên.
2.1. Nguyên vật liệu
Vi khuẩn: Các mẫu vi khuẩn sử dụng trong nghiên cứu, gồm: Bacillus subtilis ATCC 6633; Geobacillus stearothermophilus ATCC 7953; Pseudomonas aeruginosa ATCC 9027; Staphylococcus aureus ATCC 25023; Staphylococcus aureus ATCC 25923; Escherichia coli ATCC 85922; Escherichia coli ATCC 35218; Escherichia coli ATCC 25922 và Salmonella ATCC 13311, được mua từ Viện Công nghệ sinh học, đại học Quốc gia Hà Nội và lưu trữ tại phòng thí nghiệm (Bộ môn Nội – Chẩn – Dược, khoa Thú y, Học viện Nông nghiệp Việt Nam).
Dược liệu: Dược liệu là toàn bộ phần thân lá của cây xuyên tâm liên trên mặt đất, được thu hoạch và sơ chế vởi công ty dược liệu cổ truyền An Bình (Nghĩa Trai, Hưng Yên).
2.2. Phương pháp nghiên cứu
Mẫu khô dược liệu được nghiền thành bột mịn và sàng qua sàng chuyên dụng để đảm bảo đường kính của các hạt là < 0,5mm. Bột dược liệu sau đó được chiết xuất với sáu dung môi có độ phân cực khác nhau thường dùng trong chiết xuất thực vật, bao gồm: ethanol, methanol, nước nóng, ethyl acetat, aceton, hexan. Với dung môi hữu cơ, việc chiết xuất được thực hiện theo phương pháp ngâm tại ở nhiệt độ phòng trong 24 giờ với tỷ lệ bột dược liệu/ dung môi là 1/30 (cứ 10 g dược liệu trộn với 300 ml dung môi). Với dung môi nước nóng, dược liệu được trộn đều với dung môi cũng với tỷ lệ 1/30, nhưng không ngâm qua đêm mà sử dụng máy khuấy từ để đảo trộn liên tục trong vòng 30 phút. Với nước, chúng tôi không dùng phương pháp ngâm tại nhiệt độ phòng như với các dung môi hữu cơ mà sử dụng yếu tố nhiệt độ cao, đó là vì so với nước nóng, nước lạnh thường có khả năng hòa tan kém hơn các thành phần có hoạt tính của nguyên liệu thực vật. Hỗn dịch của dược liệu và dung môi sau đó được lọc bỏ hết cặn và đem cô tại áp suất thấp để loại hết dung môi.
Trong thí nghiệm với vi khuẩn, các cao được hòa tan trở lại với Dimethyl Sulfoxide (DMSO) theo tỷ lệ 2 g dược liệu khô trên 1ml DMSO (do khối lượng của cao quá nhỏ nên tính toán hàm lượng dựa theo khối lượng bột dược liệu thô ban đầu đem chiết xuất, theo cách tính tương tự của Ha Thi Thanh Nguyen [4, 5]. Từ dung dịch khởi đầu này, dịch chiết cũng sẽ tiếp tục được pha loãng cho đến các nồng độ thử nghiệm tiếp theo bằng dung môi DMSO. Sở dĩ chúng tôi lựa chọn DMSO để pha loãng cao là do đây là dung môi có khả năng hòa tan cao được chiết xuất bởi nhiều dung môi khác, và bản thân DMSO lại không có tính độc, không ảnh hưởng đến sự phát triển của vi khuẩn.
Để khảo sát tác dụng kháng khuẩn bằng phương pháp khuyếch tán trên thạch của Kirby-Bauer, sử dụng canh khuẩn có nồng độ 106 cfu/ml. Nồng độ 106 cfu/ml là nồng độ tiêu chuẩn được sử dụng trong các phương xác định hoạt lực kháng khuẩn của kháng sinh bằng nguyên lý khuyếch tán trên thạch [6, 7, 8]. Khả năng ức chế sự phát triển của vi khuẩn được xác định theo phương pháp đục giếng trên thạch, sử dụng nguyên lý khuếch tán của Kirby-Bauer [9, 10, 11]
Các đĩa vi khuẩn có nồng độ thích hợp 106 cfu/ml được sử dụng để đục giếng nhr dịch chiết. Sau khi bề mặt thạch đã khô, chúng tôi sử dụng các dụng cụ đục lỗ bằng đồng có đường kính bên trong lòng ống là 1cm để đục và tạo ra từ 3 đến 4 giếng bên trong lòng đĩa, sao cho các đĩa tâm đĩa một khoảng giống nhau và cách đều nhau. Cuối cùng, chúng tôi nhỏ vào mỗi giếng 100 µl của chất kháng khuẩn cần thử nghiệm. Những đĩa thạch này tiếp đó được để trong tủ mát tại nhiệt độ 15 o C trong 3 tiếng để dịch chiết khuếch tán hết ra bề mặt thạch [12] rồi chuyển sang tủ nuôi với điều kiện nhiệt độ là 37 0C được duy trì trong thời gian 24 tiếng. Các đĩa vi khuẩn sau đó được lấy ra quan sát để đánh giá khả năng ức chế sự phát triển của chất thử nghiệm lên vi khuẩn, thông qua việc xác định độ lớn của đường kính vòng vô khuẩn được tạo ra xung quanh các giếng có nhỏ chất thử nghiệm.
Hàm lượng polyphenol tổng số trong dịch chiết được xác định theo phương pháp của Suda & cs. [13]; còn hoạt tính chống oxi hóa được xác định theo phương pháp của Masuda & cs. [14], sử dụng cơ chất DPPH (2,2-Diphenyl-1-Picrylhydrazyl).
Khả năng chống oxy hóa của mẫu thí nghiệm được tính toán theo công thức:
Ac-As-Ab
AA % = ——————- x 100
Ac
Trong đó:
Ac= Giá trị mật độ quang (OD) của ống đối chứng
As = Giá trị mật độ quang (OD) của ống thí nghiệm
Ab = Giá trị mật độ quang (OD) của ống đối chứng âm
Axit chlorogenic (Merck, Đức) được sử dụng làm chất chuẩn để quy đổi hàm lượng polyphenol tổng số, còn VTM E (alpha-Tocopherol, Merck, Đức) được sử dụng làm chất chuẩn để quy đổi hoạt tính chống oxi hóa, theo đó hàm lượng polyphenol tổng số và hoạt tính chống oxi hóa tương đương của100 mg bột dược liệu sẽ được quy đổi sang số mg acid chlorogenic và VTME tương ứng.
- d) Phương pháp xử lý số liệu: Số liệu thu được xử lý theo phương pháp thống kê sinh học trên phần mềm Excel.
3.1. Hoạt tính kháng khuẩn của dịch chiết xuyên tâm liên
Đường kính vòng vô khuẩn tạo ra bởi dịch chiết xuyên tâm liên với các nồng độ khác nhau trên 9 vi khuẩn thử nghiệm được chúng tôi thể hiện ở bảng 1 và ảnh 1.
Bảng 1. Đường kính vòng vô khuẩn (mm) của cao dược liệu xuyên tâm liên.
| Vi khuẩn | Dung môi | Nồng độ dịch chiết | ||||
| 250mg/ml | 500mg/ ml | 1000mg/ml | 2000mg/ ml | |||
| Gram + | B.subtilis 6633 | Nước nóng | 0.00±0.00 | 2.12±1.71 | 4.85±1.35 | 6.04±0.01 |
| Methanol | 6.67±0.91 | 6.84±0.30 | 6.91±0.20 | 7.25±0.00 | ||
| Ethanol | 3.61±0.21 | 5.81±3.35 | 8.49±0.10 | 9.37±0.25 | ||
| Ethyl acetate | 4.8±3.15 | 4.55±2.84 | 7.84±1.67 | 7.34±2.63 | ||
| Aceton | 4.55±1.00 | 6.82±0.57 | 7.35±0.39 | 9.04±0.00 | ||
| G. philus 7953 | Nước nóng | 0.00±0.00 | 1.73±0.19 | 4.7±1.21 | 6.52±0.38 | |
| Methanol | 5.21±0.16 | 6.51±0.37 | 8.39±0.52 | 9.54±0.49 | ||
| Ethanol | 3.95±0.4.03 | 4.82±1.56 | 8.26±0.77 | 9.25±0.09 | ||
| Ethyl acetate | 3.84±2.71 | 8.59±0.29 | 9.74±0.27 | 9.8±0.32 | ||
| Aceton | 4.68±0.00 | 6.76±1.21 | 8.29±0.55 | 9.05±0.01 | ||
| S. aureus 25923 | Ethanol | 3.86±0.45 | 6.12±1.37 | 6.96±0.43 | 7.38±0.32 | |
| S. aureus 25023 | Ethanol | 0.00±0.00 | 0.00±0.00 | 8.59±0.74 | 15.35±1.21 | |
| Gram – | E. coli 25922 | Ethanol | 0.00±0.00 | 0.00±0.00 | 14.51±2.82 | 18.81±2.22 |
| E.coli 85922 | Ethanol | 0.00±0.00 | 2.12±2.99 | 11.03±033 | 15.97±0.33 | |
| E.coli 35218 | Ethanol | 0.00±0.00 | 1.96±2.77 | 6.14±0.14 | 11.35±0.46 | |
| Salmonella 13311 | Ethanol | 0.00±0.00 | 0.00±0.00 | 3.79±5.35 | 13.19±1.32 | |
| P. aeroginosa 9027 | Ethanol | 0.00±0.00 | 1.64±2.31 | 1.78±2.52 | 8.71±3.98 | |
Ghi chú: Các dịch chiết không có đường kính vòng vô khuẩn tại mọi nồng độ khảo sát không được biểu diễn ở trên bảng.
Hình Ảnh khả năng ức chế của dịch chiết xuyên tâm liên ở các dung môi: nước nóng, ethanol và methanol trên vi khuẩn Staphylococcus aureus 25023 sau 24 giờ nuôi cấy
Từ Bảng 1 ta thấy kích thước đường kính vòng vô khuẩn tỉ lệ thuận nồng độ dịch chiết các dung môi. Dịch chiết dung môi ethanol cho đường kính vòng vô khuẩn lớn nhất là 18.81 ± 2.22 mm tại nồng độ 2000 mg/ml. Trong số các dung môi khảo sát, dịch chiets ethanol cũng la dịch chiết tốt nhất khi cho tác dụng trên cả 9 vi khuẩn. Mishra và cs [15] báo cáo rằng sự đồng hiện của protein andrographolide và arabinogalactan trong dịch chiết ethanol đã được thừa nhận vì hoạt tính kháng khuẩn tăng cường của nó so với chỉ có protein andrographolide hoặc arabinogalactan. Điều này có thể phần nào giải thích tác dụng ưu việt của ethanol so với các dung môi khác. Bên cạnh đó, các hoạt chất có tính kháng khuẩn trong thực vật như các hợp chất polyphenol thường kém tan trong nước hơn so với các dung môi hữu cơ, trong khi hầu hết các thành phần có khả năng ức chế vi sinh vật phát triển của thực vật đã được xác định là có khả năng tan vào các dung môi rượu, đặc biệt là ethanol [16].
3.2. Kết quả xác định hàm lượng polyphenol và hoạt tính chống oxi hóa của dịch chiết xuyên tâm liên
Kết quả đo hàm lượng polyphenol được thể hiện ở Bảng 2 và Bảng 3.
Bảng 2 Hàm lượng polyphenol dược liệu xuyên tâm liên (số mg acid chlorogenic quy đổi tương đương trong 100 mg dược liệu thô)
| Dung môi | Hàm lượng polyphenol (số mg acid chlorogenic quy đổi tương đương trong 100 mg dược liệu thô) |
| Nước nóng | 0.163±0.080 |
| Methanol | 0.270±0.019 |
| Ethanol | 0.120±0.026 |
| Ethyl acetate | ND |
| Acetone | 0.033±0.016 |
| Hexan | ND |
Ghi chú : “ND ” not detected
Kết quả ở bảng 2 cho thấy hàm lượng polyphenol của xuyên tâm liên cao nhất là với dung môi methanol, tiếp đó là nước nóng, ethanol và acetone. Trong khi đó, hàm lượng này trong dung môi ethyl acetate và hexan là quá thấp nên không thể ghi nhận được sự chuyển màu của thuốc thử.
Bảng 3. Hoạt tính chống oxy của xuyên tâm liên (số mg VTME quy đổi tương đương trong 100mg dược liệu thô).
| Dung môi | Hoạt tính chống oxi hóa (số mg VTME quy đổi tương đương trong 100 mg dược liệu thô) |
| Nước nóng | 0.691±0.115 |
| Metanol | 0.555±0.152 |
| Ethanol | 0.150±0.029 |
| Ethyl acetate | nd |
| Acetone | 0.075±0.013 |
| Hexan | nd |
Ghi chú : “ND ” not detected
Từ bảng 3 chúng ta thấy hoạt tính chống oxi hóa của xuyên tâm liên đạt cao nhất khi được chiết xuất bởi nước nóng là 0.691±0.115 (mg VTME quy đổi/ 100 mg dược liệu thô), tiếp đến methanol là 0.555±0.152 (mg VTME quy đổi/ 100 mg dược liệu thô), rồi đến ethanol và acetone. Dịch chiết dung môi ethyl và hexane có hoạt tính oxi hóa thấp, và không xác định được bằng phương pháp sử dụng thuốc thử DPPH.

Hình 2. Sự thay đổi màu của các dung môi dược liệu xuyên tâm liên nồng độ 20 mg dược liệu.
Như vậy, chúng ta thấy trong số các dung môi khảo sát, thì methanol, nước cất, ethanol và aceton là những dung môi giúp thu được hàm lượng polyphenol cao và hoạt tính chống oxi hóa tốt. Ngược lại, dịch chiết với ethyl acetate và hexane cho hiệu quả thấp.
- KẾT LUẬN VÀ KHUYẾN NGHỊ
Kết luận:
Qua kết quả nghiên cứu chúng tôi đã sơ bộ chứng minh được tác dụng kháng khuẩn xuyên tâm liên trên 9 vi khuẩn Escheria coli ATCC 25922; Escheria coli ATCC 35218; Escheria coli ATCC 85922; Staphylococcus aureus ATCC 25923; Staphylococcus aureus ATCC 25023; Pseudomonas aeruginosa ATCC 9027; Bacillus subtilis ATCC 7953; Geobacillus stearothemophillus ATCC 7953; Salmonella ATCC 11311. Điều này góp phần giải thích cho việc dược liệu này được ứng dụng trong y học cổ truyền cho các chứng nhiễm khuẩn. Trong 6 dung môi khảo sát, dung môi ethanol cho kích thước vòng vô khuẩn lớn nhất và cũng cho hoạt tính trên nhiều vi khuẩn nhất. Vì thế, dịch chiết với dung môi này nên được tìm hiểu sâu hơn ở các nghiên cứu tiếp theo nhằm phát huy tiềm năng trong thực tiễn. Kết quả khảo sát cũng cho thấy xuyên tâm liên có hàm lượng polyphenol và hoạt tính chống oxy hoá, nhưng phụ thuộc theo dung môi chiết xuất. Việc nghiên cứu khảo sát thêm với các dung môi khác, cũng như xác định hoạt chất chính trong mỗi dung môi ở các nghiên cứu tiếp theo có thể giúp tìm ra được dung môi ưu viết nhất cho dược liệu xuyên tâm liên.
LỜI CẢM ƠN: Nghiên cứu này được thực hiện với sự hỗ trợ một phần kinh phí từ đề tài cấp Học viện Nông Nghiệp Việt Nam: “ Nghiên cứu tạo chế phẩm từ dược liệu dùng làm thức ăn bổ sung thay thế kháng sinh nhằ nâng cao khả năng miễn dịch, phòng bệnh và kích thích tăng trưởng cho gà”, mã số: T2021-12-12TĐ.
TÀI LIỆU THAM KHẢO
- Sanower Hossain, Zannat Urbi, Abubakar Sule and K. M. Hafizur Rahman. Andrographis paniculata (Burm. f.) Wall. ex Nees: A Review of Ethnobotany, Phytochemistry, and Pharmacology. ScientificWorldJournal. 2014; 2014: 274905.
- Gorinstein, S., Cvikrova, M., Machackova, I., Haruenkit, R., Park, Y.S., Jung, S.T.,
Yamamoto, K., Ayala, A.L.M., Katrich, E., Trakhtenberg, S., 2004. Characteriza-
tion of antioxidant compounds in Jaffa sweeties and white grapefruits. Food
84, 503–510. - Gorinstein, S., Martin-Belloso, O., Park, Y.-S., Haruenkit, R., Lojek, A., Ciz, M., Caspi, A., Libman, I., Trakhtenberg, S., 2001. Comparison of some biochemical characteristics of different citrus fruits. Food Chem. 74, 309–315.
- Ha Thi Thanh Nguyen, Hai Thanh Nguyen, Md Zahorul Islam, Takeshi Obi, Pitchaya Pothinuch, Phyu Phyu Khine Zar, De Xing Hou, Thanh Van Nguyen, Tuong Manh Nguyen, Cuong Van Dao, Mitsuya Shiraishi, Atsushi Miyamoto. 2016a. Pharmacological characteristics of Artemisia vulgaris L. in isolated porcine basilar artery. J Ethnopharmacol, 182:16-26. DOI: 1016/j.jep.2016.02.009.
- Ha Thi Thanh Nguyen, Hai Thanh Nguyen, Md Zahorul Islam, Takeshi Obi, Pitchaya Pothinuch, Thanh Van Nguyen, Tuong Manh Nguyen, Cuong Van Dao, Mitsuya Shiraishi, Atsushi Miyamoto. 2016b. Antagonistic Effects of Gingko biloba and Sophora japonica on Cerebral Vasoconstriction in Response to Histamine, 5-Hydroxytryptamine, U46619 and Bradykinin. Am J Chin Med. 44(8):1607-1625. doi: 10.1142/S0192415X16500907.
- Nguyễn Thanh Hà. Phương pháp kỹ thuật khoanh giấy kháng sinh khuếch tán. Kỹ thuật xét nghiệm vi sinh vật Y học. Nhà xuất bản Y học, Hà nội, 1991:329-338.
- Hudzicki & Jan (2009). Kirby-Bauer Disk Diffusion Susceptibility Test Protocol (2020). Retrieved from https://asm.org/getattachment/2594ce26-bd44-47f6-8287-0657aa9185ad/Kirby-Bauer-Disk-Diffusion-Susceptibility-Test-Protocol-pdf.pdf on March 22.
- Clinical Laboratory Standards Institute (2010). Performance standards for antimicrobial susceptibility testing twentieth informational supplement M100-S20. 30(1).
- Mounyr Balouiri, Moulay Sadiki and Saad Koraichi Ibnsouda. 2016. Methods for in vitro evaluating antimicrobial activity: A review. J Pharm Anal. 6(2): 71–79. oi: 1016/j.jpha.2015.11.005
- Gonelimali FD, Lin J, Miao W, Xuan J, Charles F, Chen M and Hatab SR (2018). Antimicrobial Properties and Mechanism of Action of Some Plant Extracts Against Food Pathogens and Spoilage Microorganisms. Front. Microbiol. 9:1639. doi: 10.3389/fmicb.2018.01639
- Sarita Manandhar, Shisir Luitel and Raj Kumar Dahal. 2019. In Vitro Antimicrobial Activity of Some Medicinal Plants against Human Pathogenic Bacteria. J Trop Med. 2019: 1895340. doi: 1155/2019/1895340
- Bùi Thị Tho và Nguyễn Thị Thanh Hà. 2009. Giáo trình Dược liệu thú y. Nhà xuất bản Đại Học Nông nghiệp 1.
- Suda, I., T. Oki, Y. Nishiba, M. Masuda, M. Kobayashi, S. Nagai, R. Hiyane & Miyashige (2005). “Polyphenol Contents and Radical-Scavenging Activity of Extracts from Fruits and Vegetables in Cultivated in Okinawa, Japan.” Journal of The Japanese Society for Food Science and Technology-nippon Shokuhin Kagaku Kogaku Kaishi – J JPN SOC FOOD SCI TECHNOL 52: 462-471.
- Masuda, T., Y. Oyama, Y. Inaba, Y. Toi, T. Arata, Y. Takeda, K. Nakamoto, H. Kuninaga, S. Nishizato & Nonaka (2002). “Antioxidant-Related Activities of Ethanol Extracts from Edible and Medicinal Plants Cultivated in Okinawa, Japan.” NIPPON SHOKUHIN KAGAKU KOGAKU KAISHI. 49: 652-661.
- Mishra, U.S.; Mishra, A.; Kumari, R.; Murthy, P.N. & Naik, B.S.(2009) Antibacterial Activity of Ethanol Extract of Andrographis paniculata. Indian J. Pharm. Sci. 71, 436–438.
- Cowan (1999). Plant products as antimicrobial agents. Clinical microbiology reviews. 12(4): 564-582.

English